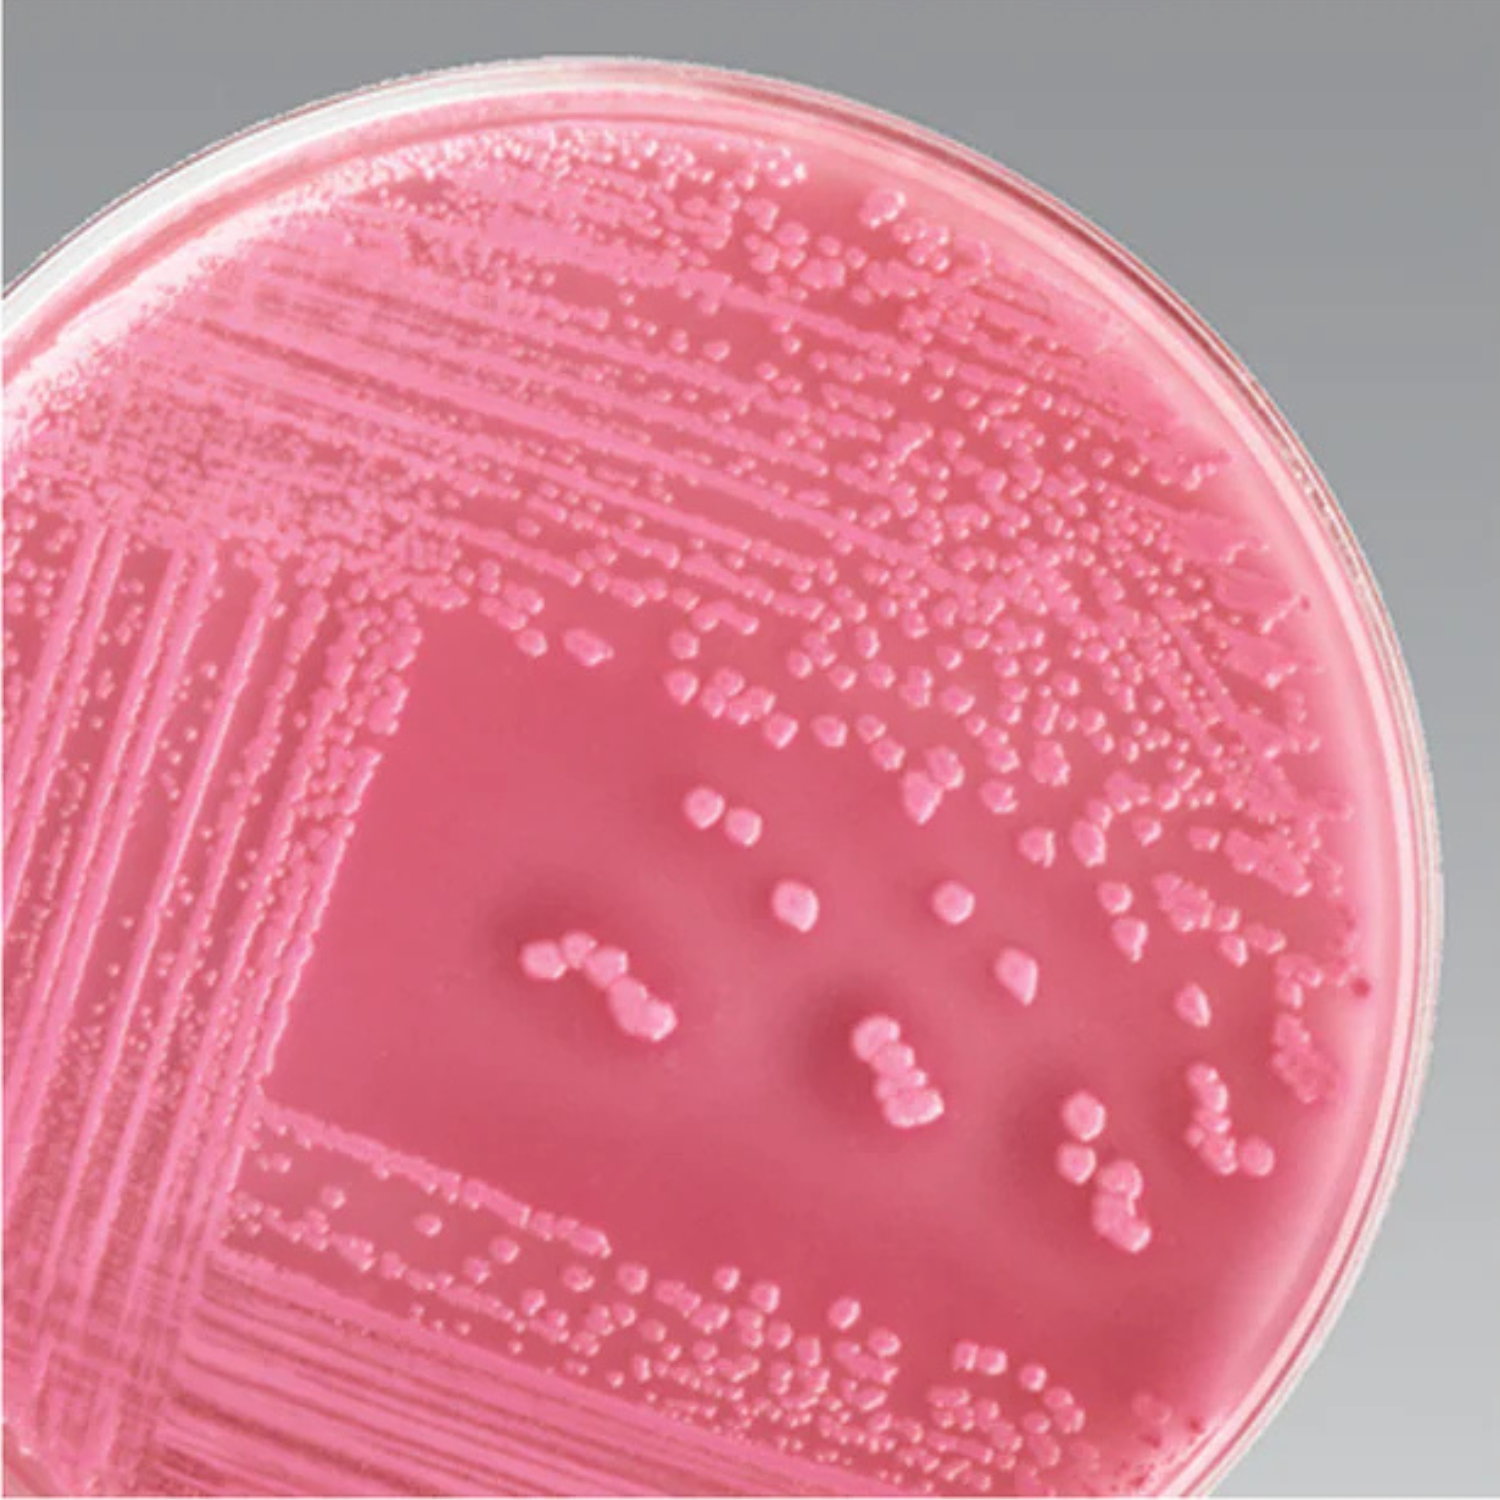
MACCONKEY AGAR 10/PK

MACCONKEY AGAR 10/PK
Detect and enumerate coliform organisms, E. coli, while isolating and detecting Salmonella and Shigella spp. in both pathological and food specimens.
Detect and enumerate coliform organisms, including E. coli, while isolating and detecting Salmonella and Shigella spp. in both pathological and food specimens using Thermo Scientific™ MacConkey Agar.
Urinary tract infections, bacteremia, meningitis, and diarrheal disease are the most frequent clinical syndromes associated with Escherichia coli. Escherichia coli O157:H7 is associated with hemorrhagic colitis and hemolytic-uremic syndrome (HUS). Escherichia coli is an aerobic, gram-negative bacillus most frequently isolated from the intestines of humans and animals. As a result, it is used as an indicator of fecal contamination in water sources. This pathogen readily grows on a variety of culture media including MacConkey Agar.
Salmonella and Shigella are major causes of bacterial enteric illness. Transmission occurs via the fecal-oral route, person-to-person contact, or by the ingestion of contaminated food or water. A relatively small number of organisms ingested is capable of causing symptomatic infection. While multidrug resistant Shigellae are prevalent, a multidrug resistant strain of Salmonella typhimurium (DT104) emerged in 1985 that is resistant to five antibiotics. Salmonella and Shigella are aerobic, gram-negative, oxidase-negative bacilli. Some Salmonella and all Shigella are nonmotile. These organisms grow on standard media, such as MacConkey Agar, SS Agar, and XLD Agar. Enrichment broths should also be used when culturing for these organisms to allow for maximum recovery.
Not all products are available for sale in all territories. Please inquire.
Remel™ and Oxoid™ products are now part of the Thermo Scientific brand, combining powerful manual, semi-automated and fully automated test products and a comprehensive line of media and diagnostic products to offer a complete, end-to-end solution to quickly deliver the products you need and the quality results your laboratory depends on.
SPECIFICATION
- Brand: Thermo Scientific
- Catalog No.: R01550
- Certifications/Compliance Industrial Reference: BAM, COMPF, SMWW, USP.
- Color: Clear pink
- Content And Storage: 2°C to 8°C
- Format: 85mm Monoplate
- Manufacturing Origin: United States
- Media Type: MacConkey Agar Medium
- Product Type: Agar
- Fill Volume: 19.5 mL
- Packaging Type: Flow Wrapped - Single Layer
- Quantity: 10/Pk.